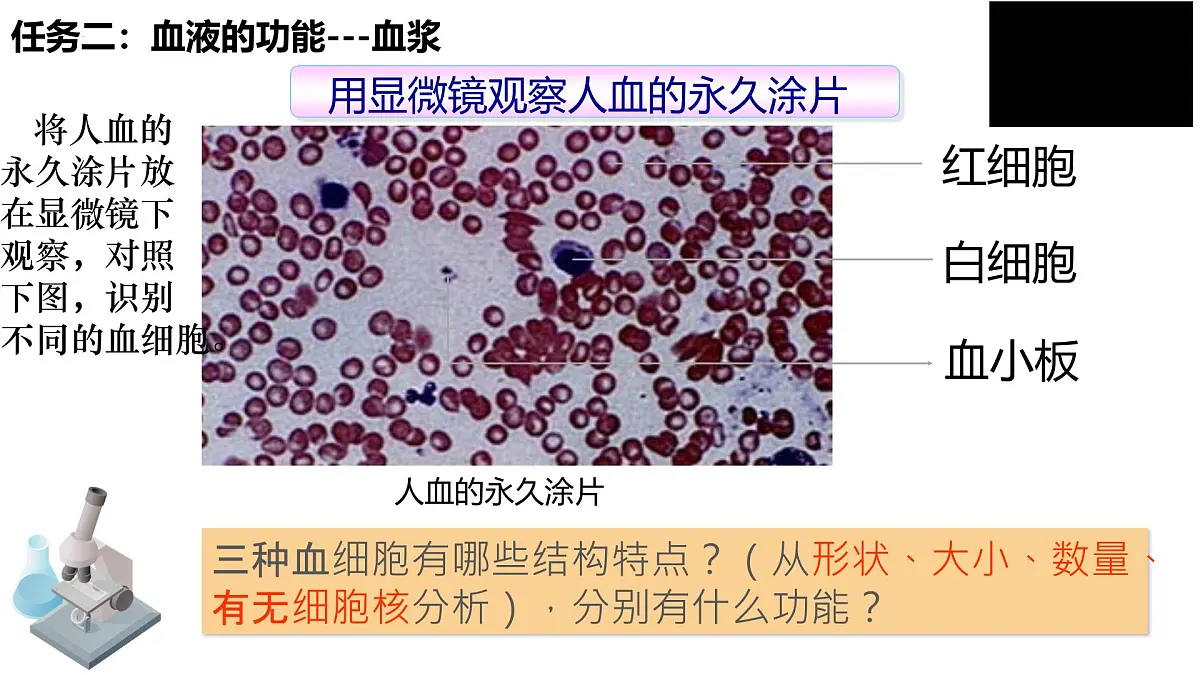
人教版生物七年级生物下册4.4.1《流动的组织——血液》课件第8页

所属成套资源:人教版七年级生物下册课件
人教版(2024)七年级下册(2024)流动的组织—血液授课课件ppt
展开 这是一份人教版(2024)七年级下册(2024)流动的组织—血液授课课件ppt,共33页。PPT课件主要包含了认识血红蛋白,血液的组成,白血病,造血干细胞,关注科学等内容,欢迎下载使用。
你知道为什么血液化验可以作为判断是否健康、诊断疾病的重要依据吗?
任务一:认识血液的成分
将一定量的人的血液放入装有抗凝剂的试管中
白细胞(WBC)血小板(PLT)
滴加抗凝剂的血液静置(离心)后分成了几层?
葡萄糖、氨基酸、无机盐等 约3%
葡萄糖、氨基酸、无机盐
任务二:血液的功能---血浆
三种血细胞有哪些结构特点?(从形状、大小、数量、有无细胞核分析),分别有什么功能?
将人血的永久涂片放在显微镜下观察,对照下图,识别不同的血细胞。
自学课本P52-54,填写学案
任务二:血液的功能---血细胞
红细胞(RBC,red bld cell)
②成熟的红细胞没有细胞核
③富含血红蛋白(Hb)
运输氧,运输部分二氧化碳
一氧化碳与血红蛋白的结合能力比氧更强
红细胞为什么呈红色呢?
红细胞呈红色,因为富含血红蛋白。
饮食建议:多吃含铁和蛋白质丰富的食物
贫血--红细胞数量过少或血红蛋白含量过低
白细胞(WBC,white bld cell)
包围、吞噬病菌;防御,保护
白细胞高于正常值很可能有致病菌的感染
如果化验单上,白细胞的数量超过正常值,那说明了什么?
你的血液中白细胞多,可能有炎症
血小板(PLT,platelet)
血小板过少会导致异常出血
释放凝血因子,血液凝固
如果血小板的数量低于正常值,会出现什么病症?高于正常值呢?
血栓:血流在心血管系统血管内面剥落处或修补处的表面所形成的小块
氧气的载体(过少,引起贫血)
运输氧气和少量二氧化碳
成熟红细胞没有细胞核,两面中间凹陷圆饼状
炎症的克星(过多,炎症)
止血的功臣(过少,血友病)
不规则,最小,无细胞核
运输氧和二氧化碳,运输营养物质和废物,防御保护作用。
血液中有大量的血细胞,这些血细胞与血浆共同构成血液,完成物质运输等功能,因此,血液是一种组织,属于结缔组织,血液可以流动,因此称作“流动的组织”。
为什么把血液称作“流动的组织”?
为挽救更多的血液病患者, 2001年12月,中央编办批准成立中国造血干细胞捐献者资料库管理中心(简称“中华骨髓库”) 。
骨髓正常造血功能受到抑制
1667年,丹尼斯等人将250毫升羊血输给了一个病人,结果当然没有成功,出现了病人死亡的悲剧。
1829年,英国医生布伦德尔第一次完成了人与人之间的输血试验。但以后的试验结果还是令人失望,大多数病人死亡,只有少数病人得到康复,这是怎么回事呢?
伤者严重失血,已昏迷。为了抢救伤者,医生决定给伤者输血。
假如你是医生,你会怎么做?
成年人体内的血量大致相当于本人体重的7%~8%。
一次失血量800~1000ml:会出现头晕、心跳加快、眼前发黑和出冷汗等症状。
一次失血量>1200~1500ml:会发生生命危险,需要及时输血。
1、以下是表示血液、血浆、血细胞之间的关系,其中正确的是 ( )
2、人体成熟的血细胞中不具有细胞核的一组是( ) A.红细胞和白细胞 B.血小板和白细胞 C.血小板和红细胞 D.血细胞和红细胞3、下列血细胞与其功能相对应中,正确的一组是( ) A.白细胞—止血和加速凝血 B.血小板—吞噬病菌 C.红细胞—运输氧气和部分二氧化碳 D.红细胞—吞噬病菌
相关课件
这是一份生物流动的组织—血液课文ppt课件,共35页。PPT课件主要包含了血液的组成,小组讨论回答问题,深红色,白色物质,血细胞,血液的组成--血浆,归纳血浆的作用,运载血细胞,链接生活,血液的组成--血细胞等内容,欢迎下载使用。
这是一份人教版(2024)七年级下册(2024)流动的组织—血液授课课件ppt,共33页。PPT课件主要包含了认识血红蛋白,血液的组成,白血病,造血干细胞,关注科学等内容,欢迎下载使用。
这是一份初中生物人教版(2024)七年级下册(2024)流动的组织—血液评课ppt课件,共28页。PPT课件主要包含了流动的组织血液,55%,血细胞,知识点1血液的组成,血浆的主要作用,白细胞吞噬病菌,贫血患者,课堂总结,概念检测,拓展应用等内容,欢迎下载使用。
相关课件 更多
- 1.电子资料成功下载后不支持退换,如发现资料有内容错误问题请联系客服,如若属实,我们会补偿您的损失
- 2.压缩包下载后请先用软件解压,再使用对应软件打开;软件版本较低时请及时更新
- 3.资料下载成功后可在60天以内免费重复下载
 免费领取教师福利
免费领取教师福利 






.png)
.png)
.png)


